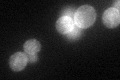
YOL020W
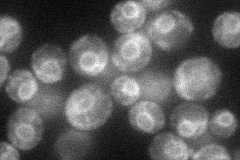
YOL020W
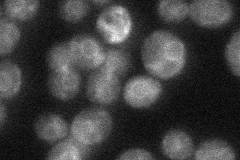
YOL020W
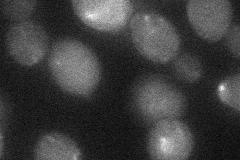
YOL020W
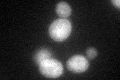
YOL020W

View description
High affinity tryptophan and tyrosine permease, overexpression confers FK506 and FTY720 resistance
Localization:
Intensity:
Fold change:
Significance:
-
C’ GFP library in SD
cell periphery57.86 -
N' NOP1pr-GFP in SD
ER41.6028 -
N' TEF2pr-mCherry in SD

ER,vacuole39.9192 -
N' NATIVEpr-GFP in SD
ER25.8543 -
N' TEF2pr-VC and Cyto-VN in SD
below threshold29.9765 -
C’ GFP library in SD+DTT
cell periphery36.170.62No -
C’ GFP library in SD+H2O2

punctateN/AN/ANo -
C’ GFP library in Starvation Media

cell periphery17.790.3Yes -
C’ GFP library on the background of Pup2-DaMP

cell periphery -
C’ GFP library on the background of CCT mutant

cell periphery53.35920.922137No
